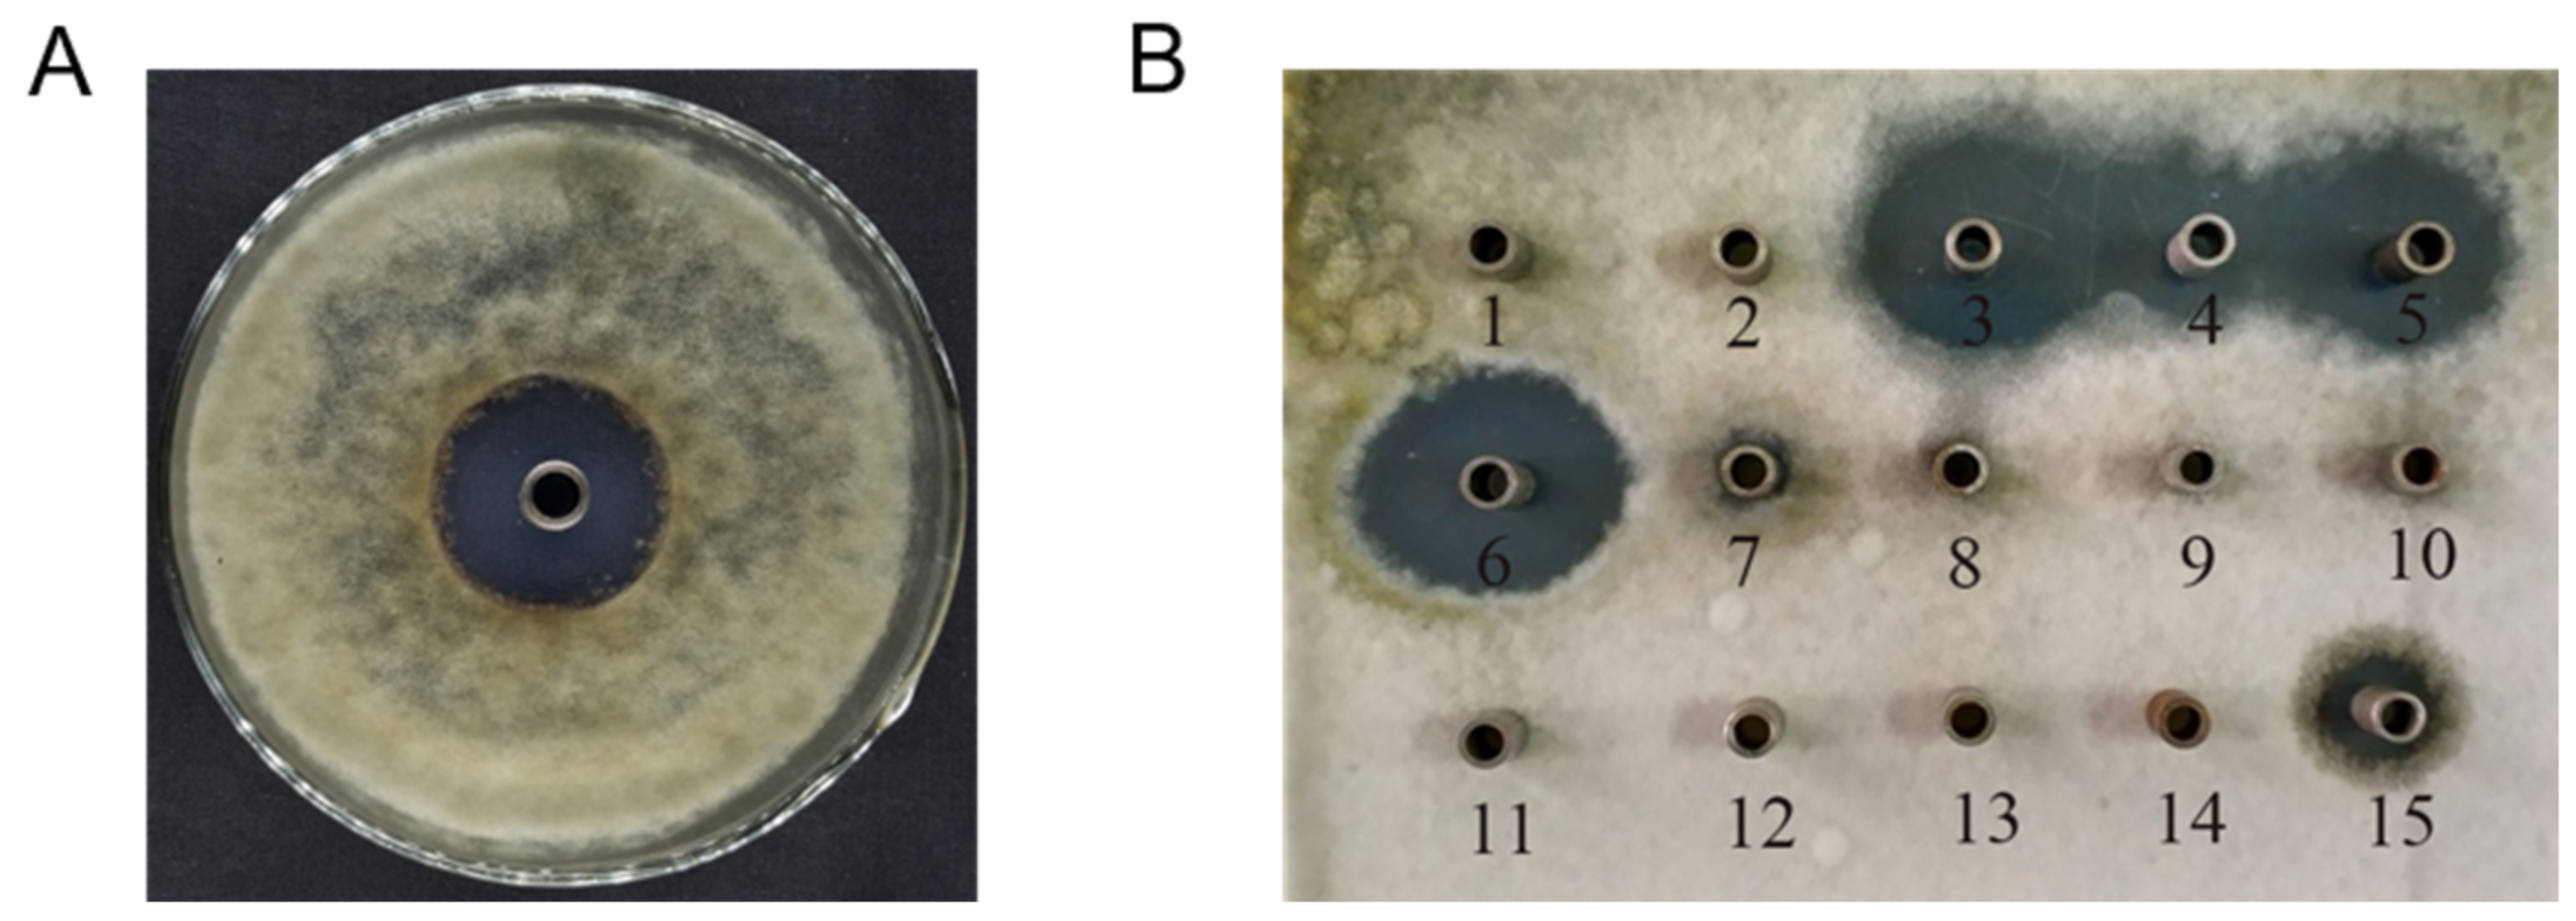

Identification of Cyclic Dipeptides and a New Compound (6-(5-Hydroxy-6-methylheptyl)-5,6-dihydro-2H-pyran-2-one) Produced by Streptomyces fungicidicus against Alternaria solani
Abstract
1. Introduction
2. Results
2.1. Anti-A. solani Activity of the SYH3 Fermentation Broth and Its Purified Products
2.2. Structural Identification of the Isolated Four Active Monomeric Compounds
2.3. Effects of Compound 4 on Spore Germination and Germ Tube Morphology
2.4. Antimicrobial Spectrum of Compound 4 against Test Pathogens
3. Discussion
4. Materials and Methods
4.1. Microorganisms, Media, and Culture Conditions
4.2. Isolation and Purification of S. fungicidicus Metabolites
4.3. Determination of Anti-A. solani Activity of Fermentation Broth and Purified Products
4.4. Determination of Anti-A. solani Activity of Fermentation Broth and Purified Products
4.5. Effects of Compound 4 on Spore Germination and Germ Tube Elongation in A. solani
4.6. Inhibitory Activity of Compound 4 against Different Pathogenic Microorganisms
5. Patents
Supplementary Materials
Author Contributions
Funding
Institutional Review Board Statement
Informed Consent Statement
Data Availability Statement
Conflicts of Interest
Sample Availability
References
- Kim, E.S. Recent advances of actinomycetes. Biomolecules 2021, 11, 134. [Google Scholar] [CrossRef] [PubMed]
- Jakubiec-Krzesniak, K.; Rajnisz-Mateusiak, A.; Guspiel, A.; Ziemska, J.; Solecka, J. Secondary metabolites of actinomycetes and their antibacterial, antifungal and antiviral properties. Pol. J. Microbiol. 2018, 67, 259–272. [Google Scholar] [CrossRef] [PubMed]
- Barka, E.A.; Vatsa, P.; Sanchez, L.; Gaveau-Vaillant, N.; Jacquard, C.; Meier-Kolthoff, J.P.; Klenk, H.P.; Clément, C.; Ouhdouch, Y.; van Wezel, G.P. Taxonomy, physiology, and natural products of actinobacteria. Microbiol. Mol. Biol. Rev. 2016, 80, 1–43. [Google Scholar] [CrossRef] [PubMed]
- Hopwood, D.A. How do antibiotic-producing bacteria ensure their self-resistance before antibiotic biosynthesis incapacitates them? Mol. Microbiol. 2007, 63, 937–940. [Google Scholar] [CrossRef] [PubMed]
- Labeda, D.P.; Goodfellow, M.; Brown, R.; Ward, A.C.; Lanoot, B.; Vanncanneyt, M.; Swings, J.; Kim, S.B.; Liu, Z.; Chun, J.; et al. Phylogenetic study of the species within the family Streptomycetaceae. Antonie Van Leeuwenhoek 2012, 101, 73–104. [Google Scholar] [CrossRef] [PubMed]
- Harada, S.; Kishi, T. Isolation and characterization of mildiomycin, a new nucleoside antibiotic. J. Antibiot. (Tokyo) 1978, 31, 519–524. [Google Scholar] [CrossRef]
- Ikeno, S.; Aoki, D.; Hamada, M.; Hori, M.; Tsuchiya, K.S. DNA sequencing and transcriptional analysis of the kasugamycin biosynthetic gene cluster from Streptomyces kasugaensis M338-M1. J. Antibiot. (Tokyo) 2006, 59, 18–28. [Google Scholar] [CrossRef] [PubMed]
- Yoshinari, T.; Watanabe, M.; Hara-Kudo, Y. Cross-genus inhibitory activity of polyoxins against aflatoxin production by Aspergillus parasiticus and fumonisin production by Fusarium fujikuroi. FEMS Microbiol. Lett. 2022, 369, fnac048. [Google Scholar] [CrossRef] [PubMed]
- Copping, L.G.; Duke, S.O. Natural products that have been used commercially as crop protection agents. Pest. Manag. Sci. 2007, 63, 524–554. [Google Scholar] [CrossRef]
- Li, X.; Wu, P.; Li, H.; Xue, J.; Xu, H.; Wei, X. Antibacterial and cytotoxic phenyltetracenoid polyketides from Streptomyces morookaense. J. Nat. Prod. 2021, 84, 1806–1815. [Google Scholar] [CrossRef]
- Saadouli, I.; Zendah El Euch, I.; Trabelsi, E.; Mosbah, A.; Redissi, A.; Ferjani, R.; Fhoula, I.; Cherif, A.; Sabatier, J.M.; Sewald, N.; et al. Isolation, characterization and chemical synthesis of large spectrum antimicrobial cyclic dipeptide (l-leu-l-pro) from Streptomyces misionensis V16R3Y1 bacteria extracts. A Novel (1)H NMR Metabolomic Approach. Antibiotics 2020, 9, 270. [Google Scholar] [CrossRef] [PubMed]
- Arora, S.K. Molecular structure of heliomycin, an inhibitor of RNA synthesis. J. Antibiot. (Tokyo) 1985, 38, 113–115. [Google Scholar] [CrossRef] [PubMed][Green Version]
- Sallam, N.J.P.P.J. Control of tomato early blight disease by certain aqueous plant extracts. Plant Pathology J. 2011, 10, 187–191. [Google Scholar] [CrossRef]
- Yadav, O.P.; Dabbas, M.R.; Gaur, L.B.J.P.A. Screening of tomato advanced lines, genotypes against Alternaria solani. Plant Archives. 2014, 14, 553–555. [Google Scholar]
- Saha, S.; Purath, A.S.; Jadhav, M.R.; Loganathan, M.; Banerjee, K.; Rai, A.B. Bioefficacy, residue dynamics and safety assessment of the combination fungicide trifloxystrobin 25% + tebuconazole 50%-75 WG in managing early blight of tomato (Lycopersicon esculentum Mill.). J. Environ. Sci. Health B 2014, 49, 134–141. [Google Scholar] [CrossRef] [PubMed]
- Cohen, Y.; Rubin, A.E. A new strategy for durable control of late blight in potato by a single soil application of an oxathiapiprolin mixture in early season. PLoS ONE 2020, 15, e0238148. [Google Scholar]
- Sun, Y.F.; Liu, Z.; Li, H.Y.; Zheng, Z.H.; Ji, C.L.; Guo, Q.; Lai, H.X. Biocontrol effect and mechanism of Bacillus laterosporus Bl13 against early blight disease of tomato. Chinese J. Appl. Ecol. 2021, 32, 299–308. (In Chinese) [Google Scholar]
- Brooks, S.; Klomchit, A.; Chimthai, S.; Jaidee, W.; Bastian, A.C. Xylaria feejeensis, SRNE2BP a fungal endophyte with biocontrol properties to control early blight and Fusarium wilt disease in tomato and plant growth promotion activity. Curr. Microbiol. 2022, 79, 108. [Google Scholar] [CrossRef] [PubMed]
- El Deeb, K.S.; Eid, H.H.; Ali, Z.Y.; Shams, M.M.; Elfiky, A.M. Bioassay-guided fractionation and identification of antidiabetic compounds from the rind of Punica Granatum Var. nana. Nat. Prod. Res. 2021, 35, 2103–2106. [Google Scholar] [CrossRef] [PubMed]
- Vasconcelos, E.A.; Santana, C.G.; Godoy, C.V.; Seixas, C.D.; Silva, M.S.; Moreira, L.R.; Oliveira-Neto, O.B.; Price, D.; Fitches, E.; Filho, E.X.; et al. A new chitinase-like xylanase inhibitor protein (XIP) from coffee (Coffea arabica) affects Soybean Asian rust (Phakopsora pachyrhizi) spore germination. BMC Biotechnol. 2011, 11, 14. [Google Scholar] [CrossRef] [PubMed]
- Huang, X.; You, Z.; Luo, Y.; Yang, C.; Ren, J.; Liu, Y.; Wei, G.; Dong, P.; Ren, M. Antifungal activity of chitosan against Phytophthora infestans, the pathogen of potato late blight. Int. J. Biol. Macromol. 2021, 166, 1365–1376. [Google Scholar] [CrossRef] [PubMed]
- Li, Z.B.; Sun, H.Y.; Zhao, J.X.; Zhou, J.W.; Liang, D.; Gao, Y. Screening and identification of Streptomyces fungicidicus strain AL-04. Biotechn. Bull. 2014, 5, 155–161. (In Chinese) [Google Scholar]
- Ramesh, S.; Rajesh, M.; Mathivanan, N. Characterization of a thermostable alkaline protease produced by marine Streptomyces fungicidicus MML1614. Bioprocess Biosyst. Eng. 2009, 32, 791–800. [Google Scholar] [CrossRef] [PubMed]
- Wen, C.Y.; Bai, J.B.; Wu, Y.H. Screening of agriantibiotic TS99 high-production strain. Microbiol. China 2008, 35, 384–388. (In Chinese) [Google Scholar]
- Li, X.; Dobretsov, S.; Xu, Y.; Xiao, X.; Hung, O.S.; Qian, P.Y. Antifouling diketopiperazines produced by a deep-sea bacterium, Streptomyces fungicidicus. Biofouling 2006, 22, 201–208. [Google Scholar] [CrossRef] [PubMed]
- Pan, C.M.; Wang, J.; Zhang, X.J. Study on variable temperature control strategy of enramycin production by Streptomyces fungicidicus. Feed Ind. 2014, 35, 26–28. (In Chinese) [Google Scholar]
- Jia, B.; Ma, Y.M.; Liu, B.; Chen, P.; Hu, Y.; Zhang, R. Synthesis, antimicrobial activity, structure-activity relationship, and molecular docking studies of indole diketopiperazine alkaloids. Front. Chem. 2019, 7, 837. [Google Scholar] [CrossRef] [PubMed]
- Huang, R.M.; Yi, X.X.; Zhou, Y.; Su, X.; Peng, Y.; Gao, C.H. An update on 2,5-diketopiperazines from marine organisms. Mar. Drugs. 2014, 12, 6213–6235. [Google Scholar] [CrossRef]
- Wang, J.H.; Yang, C.Y.; Fang, S.T.; Lu, J.; Quan, C.S. Inhibition of biofilm in Bacillus amyloliquefaciens Q-426 by diketopiperazines. World J. Microbiol. Biotechnol. 2016, 32, 143. [Google Scholar] [CrossRef] [PubMed]
- Huang, R.; Zhou, X.; Xu, T.; Yang, X.; Liu, Y. Diketopiperazines from marine organisms. Chem. Biodivers. 2010, 7, 2809–2829. [Google Scholar] [CrossRef]
- Bojarska, J.; Mieczkowski, A.; Ziora, Z.M.; Skwarczynski, M.; Toth, I.; Shalash, A.O.; Parang, K.; El-Mowafi, S.A.; Mohammed, E.H.M.; Elnagdy, S.; et al. Cyclic dipeptides: The biological and structural landscape with special focus on the anti-cancer proline-based scaffold. Biomolecules 2021, 11, 1515. [Google Scholar] [CrossRef] [PubMed]
- Wang, Y.; Wang, P.; Ma, H.; Zhu, W. Developments around the bioactive diketopiperazines: A patent review. Expert Opin. Ther. Pat. 2013, 23, 1415–1433. [Google Scholar] [CrossRef] [PubMed]
- Teixidó, M.; Zurita, E.; Malakoutikhah, M.; Tarragó, T.; Giralt, E. Diketopiperazines as a tool for the study of transport across the blood-brain barrier (BBB) and their potential use as BBB-shuttles. J. Am. Chem. Soc. 2007, 129, 11802–111803. [Google Scholar] [CrossRef] [PubMed]
- Ortiz-Castro, R.; Díaz-Pérez, C.; Martínez-Trujillo, M.; del Río, R.E.; Campos-García, J.; López-Bucio, J. Transkingdom signaling based on bacterial cyclodipeptides with auxin activity in plants. Proc. Natl. Acad. Sci. USA 2011, 108, 7253–7258. [Google Scholar] [CrossRef] [PubMed]
- Wang, F.; Wang, F.; Chen, T. Secondary metabolites of Galactomyces geotrichum from Laminaria japonica ameliorate cognitive deficits and brain oxidative stress in D-galactose induced Alzheimer’s disease mouse model. Nat. Prod. Res. 2021, 35, 5323–5328. [Google Scholar] [CrossRef] [PubMed]
- Ström, K.; Sjögren, J.; Broberg, A.; Schnürer, J. Lactobacillus plantarum MiLAB 393 produces the antifungal cyclic dipeptides cyclo(L-Phe-L-Pro) and cyclo(L-Phe-trans-4-OH-L-Pro) and 3-phenyllactic acid. Appl. Environ. Microbiol. 2002, 68, 4322–4327. [Google Scholar] [CrossRef]
- Holden, M.T.; Ram Chhabra, S.; de Nys, R.; Stead, P.; Bainton, N.J.; Hill, P.J.; Manefield, M.; Kumar, N.; Labatte, M.; England, D.; et al. Quorum-sensing cross talk: Isolation and chemical characterization of cyclic dipeptides from Pseudomonas aeruginosa and other gram-negative bacteria. Mol. Microbiol. 1999, 33, 1254–1266. [Google Scholar] [CrossRef] [PubMed]
- Degrassi, G.; Aguilar, C.; Bosco, M.; Zahariev, S.; Pongor, S.; Venturi, V. Plant growth-promoting Pseudomonas putida WCS358 produces and secretes four cyclic dipeptides: Cross-talk with quorum sensing bacterial sensors. Curr. Microbiol. 2002, 45, 250–254. [Google Scholar] [CrossRef] [PubMed]
- Rhee, K.H. Cyclic dipeptides exhibit synergistic, broad spectrum antimicrobial effects and have anti-mutagenic properties. Int. J. Antimicrob. Agents. 2004, 24, 423–427. [Google Scholar] [CrossRef] [PubMed]
- Wardecki, T.; Brötz, E.; De Ford, C.; von Loewenich, F.D.; Rebets, Y.; Tokovenko, B.; Luzhetskyy, A.; Merfort, I. Endophytic Streptomyces in the traditional medicinal plant Arnica montana L.: Secondary metabolites and biological activity. Antonie Van Leeuwenhoek 2015, 108, 391–402. [Google Scholar] [CrossRef] [PubMed]
- Ma, H.; Wang, F.; Jin, X.; Jiang, J.; Hu, S.; Cheng, L.; Zhang, G. A new diketopiperazine from an endophytic fungus Aspergillus aculeatus F027. Nat. Prod. Res. 2021, 35, 2370–2375. [Google Scholar] [CrossRef] [PubMed]
- Yao, W.L.; Wang, Y.S.; Han, J.G.; Li, L.B.; Song, W. Purification and cloning of an antifungal protein from the rice diseases controlling bacterial strain Paenibacillus polymyxa WY110. Yi Chuan Xue Bao 2004, 31, 878–887. (In Chinese) [Google Scholar] [PubMed]
- Fdhila, F.; Vázquez, V.; Sánchez, J.L.; Riguera, R. dd-diketopiperazines: Antibiotics active against Vibrio anguillarum isolated from marine bacteria associated with cultures of Pecten maximus. J. Nat. Prod. 2003, 66, 1299–1301. [Google Scholar] [CrossRef] [PubMed]
- Xu, Z.; Zhang, Y.; Fu, H.; Zhong, H.; Hong, K.; Zhu, W. Antifungal quinazolinones from marine-derived Bacillus cereus and their preparation. Bioorg. Med. Chem. Lett. 2011, 21, 4005–4007. [Google Scholar] [CrossRef] [PubMed]
- Ren, S.; Ma, W.; Xu, T.; Lin, X.; Yin, H.; Yang, B.; Zhou, X.F.; Yang, X.W.; Long, L.; Lee, K.J.; et al. Two novel alkaloids from the South China Sea marine sponge Dysidea sp. J. Antibiot. (Tokyo) 2010, 63, 699–701. [Google Scholar] [CrossRef] [PubMed]
- Zhou, S.; Huang, G. Design, synthesis and biological evaluation of novel 7H-benzo [c] [1, 3] dioxolo [4, 5-f] chromen-7-one derivatives with potential anti-tumor activity. Bioorg. Chem. 2020, 105, 104381. [Google Scholar] [CrossRef] [PubMed]
- Fukami, T.; Takahashi, S.; Nakagawa, N.; Maruichi, T.; Nakajima, M.; Yokoi, T. In vitro evaluation of inhibitory effects of antidiabetic and antihyperlipidemic drugs on human carboxylesterase activities. Drug Metab. Dispos. 2010, 38, 2173–2178. [Google Scholar] [CrossRef] [PubMed]
- Ni, H.J.; Lv, S.Y.; Sheng, Y.T.; Wang, H.; Chu, X.H.; Zhang, H.W. Optimization of fermentation conditions and medium compositions for the production of chrysomycin a by a marine-derived strain Streptomyces sp. 891. Prep. Biochem. Biotechnol. 2021, 51, 998–1003. [Google Scholar] [CrossRef] [PubMed]
- Liang, W.; Li, H.; Zhou, H.; Wang, M.; Zhao, X.; Sun, X.; Li, C.; Zhang, X. Effects of taraxacum and astragalus extracts combined with probiotic Bacillus subtilis and Lactobacillus on Escherichia coli-infected broiler chickens. Poult. Sci. 2021, 100, 101007. [Google Scholar] [CrossRef] [PubMed]
- Vinuesa, M.A.; Fernández, A. A simple antifungal assay for testing actinomycetes and other microbial extracts. Methods Mol. Biol. 2021, 2296, 217–225. [Google Scholar] [PubMed]
- Sebaugh, J.L. Guidelines for accurate EC50/IC50 estimation. Pharm. Stat. 2011, 10, 128–134. [Google Scholar] [CrossRef] [PubMed]
- Liu, H.; Chen, J.; Xia, Z.; An, M.; Wu, Y. Effects of ε-poly-l-lysine on vegetative growth, pathogenicity, and gene expression of Alternaria alternata infecting Nicotiana tabacum. Pestic. Biochem. Physiol. 2020, 163, 147–153. [Google Scholar] [CrossRef] [PubMed]

| Compounds | Mycelial Growth Inhibition Rate (%) | IC50 (μg/mL) | ||||
|---|---|---|---|---|---|---|
| 0 μg/mL | 16 μg/mL | 32 μg/mL | 64 μg/mL | 128 μg/mL | ||
| Kasugamycin | 0 | 67.3 ± 5.1 | 85.1 ± 5.0 | 92.6 ± 2.5 | 94.7 ± 3.1 | 14.5 ± 0.9 d |
| 1 | 0 | 31.8 ± 7.4 | 46.0 ± 4.5 | 69.0 ± 4.2 | 81.4 ± 2.9 | 43.4 ± 2.9 a |
| 2 | 0 | 37.0 ± 5.3 | 48.2 ± 4.1 | 73.3 ± 4.5 | 81.8 ± 4.1 | 42.9 ± 1.2 a |
| 3 | 0 | 20.8 ± 4.1 | 45.9 ± 8.2 | 68.8 ± 5.0 | 75.1 ± 3.7 | 30.6 ± 1.9 b |
| 4 | 0 | 66.1 ± 5.4 | 79.2 ± 4.5 | 89.3 ± 8.8 | 93.8 ± 3.6 | 24.7 ± 0.8 c |
| Pathogens | Inhibition Zone Diameter (mm) |
|---|---|
| Alternaria solani | 38.3 ± 0.7 |
| Gibberella zeae | 21.3 ± 0.6 |
| Phytophora parasitica | 20.6 ± 0.8 |
| Botrytis cinerea | 26.8 ± 1.1 |
| Fusarium solani | 31.2 ± 1.5 |
| Alternaria alternata | 24.7 ± 0.9 |
| Rhizoctonia solani | 43.2 ± 0.9 |
| Colletotrichum capsici | 25.0 ± 0.5 |
| Fusarium oxysporum | 36.8 ± 1.6 |
| Bipolaris maydis | 36.4 ± 1.2 |
| Candida albicans | 39.5 ± 1.0 |
Publisher’s Note: MDPI stays neutral with regard to jurisdictional claims in published maps and institutional affiliations. |
© 2022 by the authors. Licensee MDPI, Basel, Switzerland. This article is an open access article distributed under the terms and conditions of the Creative Commons Attribution (CC BY) license (https://creativecommons.org/licenses/by/4.0/).
Share and Cite
Liu, H.; An, M.; Si, H.; Shan, Y.; Xu, C.; Hu, G.; Xie, Y.; Liu, D.; Li, S.; Qiu, R.; et al. Identification of Cyclic Dipeptides and a New Compound (6-(5-Hydroxy-6-methylheptyl)-5,6-dihydro-2H-pyran-2-one) Produced by Streptomyces fungicidicus against Alternaria solani. Molecules 2022, 27, 5649. https://doi.org/10.3390/molecules27175649
Liu H, An M, Si H, Shan Y, Xu C, Hu G, Xie Y, Liu D, Li S, Qiu R, et al. Identification of Cyclic Dipeptides and a New Compound (6-(5-Hydroxy-6-methylheptyl)-5,6-dihydro-2H-pyran-2-one) Produced by Streptomyces fungicidicus against Alternaria solani. Molecules. 2022; 27(17):5649. https://doi.org/10.3390/molecules27175649
Chicago/Turabian StyleLiu, He, Mengnan An, Hongyang Si, Yuhang Shan, Chuantao Xu, Gang Hu, Yunbo Xie, Dongyang Liu, Shujun Li, Rui Qiu, and et al. 2022. "Identification of Cyclic Dipeptides and a New Compound (6-(5-Hydroxy-6-methylheptyl)-5,6-dihydro-2H-pyran-2-one) Produced by Streptomyces fungicidicus against Alternaria solani" Molecules 27, no. 17: 5649. https://doi.org/10.3390/molecules27175649
APA StyleLiu, H., An, M., Si, H., Shan, Y., Xu, C., Hu, G., Xie, Y., Liu, D., Li, S., Qiu, R., Zhang, C., & Wu, Y. (2022). Identification of Cyclic Dipeptides and a New Compound (6-(5-Hydroxy-6-methylheptyl)-5,6-dihydro-2H-pyran-2-one) Produced by Streptomyces fungicidicus against Alternaria solani. Molecules, 27(17), 5649. https://doi.org/10.3390/molecules27175649







